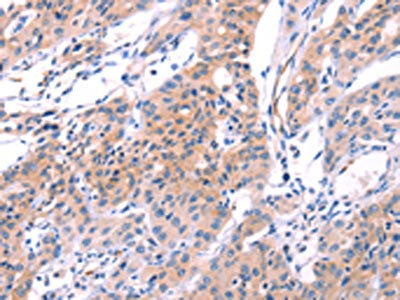

VWF Antibody
-
中文名稱:VWF兔多克隆抗體
-
貨號(hào):CSB-PA195869
-
規(guī)格:¥1100
-
圖片:
-
The image on the left is immunohistochemistry of paraffin-embedded Human lung cancer tissue using CSB-PA195869(VWF Antibody) at dilution 1/50, on the right is treated with fusion protein. (Original magnification: ×200)
-
The image on the left is immunohistochemistry of paraffin-embedded Human gastic cancer tissue using CSB-PA195869(VWF Antibody) at dilution 1/50, on the right is treated with fusion protein. (Original magnification: ×200)
-
-
其他:
產(chǎn)品詳情
-
Uniprot No.:
-
基因名:
-
別名:Coagulation factor VIII antibody; Coagulation factor VIII VWF antibody; F8VWF antibody; Factor VIII related antigen antibody; von Willebrand antigen 2 antibody; von Willebrand antigen II antibody; Von Willebrand disease antibody; Von Willebrand factor precursor antibody; VWD antibody; vWF antibody; VWF_HUMAN antibody
-
宿主:Rabbit
-
反應(yīng)種屬:Human
-
免疫原:Fusion protein of Human VWF
-
免疫原種屬:Homo sapiens (Human)
-
標(biāo)記方式:Non-conjugated
-
抗體亞型:IgG
-
純化方式:Antigen affinity purification
-
濃度:It differs from different batches. Please contact us to confirm it.
-
保存緩沖液:-20°C, pH7.4 PBS, 0.05% NaN3, 40% Glycerol
-
產(chǎn)品提供形式:Liquid
-
應(yīng)用范圍:ELISA,IHC
-
推薦稀釋比:
Application Recommended Dilution ELISA 1:2000-1:5000 IHC 1:25-1:100 -
Protocols:
-
儲(chǔ)存條件:Upon receipt, store at -20°C or -80°C. Avoid repeated freeze.
-
貨期:Basically, we can dispatch the products out in 1-3 working days after receiving your orders. Delivery time maybe differs from different purchasing way or location, please kindly consult your local distributors for specific delivery time.
-
用途:For Research Use Only. Not for use in diagnostic or therapeutic procedures.
相關(guān)產(chǎn)品
靶點(diǎn)詳情
-
功能:Important in the maintenance of hemostasis, it promotes adhesion of platelets to the sites of vascular injury by forming a molecular bridge between sub-endothelial collagen matrix and platelet-surface receptor complex GPIb-IX-V. Also acts as a chaperone for coagulation factor VIII, delivering it to the site of injury, stabilizing its heterodimeric structure and protecting it from premature clearance from plasma.
-
基因功能參考文獻(xiàn):
- High VWF expression is associated with age-related macular degeneration. PMID: 29367644
- The Plasma Levels of ADAMTS-13, von Willebrand Factor, VWFpp, and Fibrin-Related Markers in Patients With Systemic Sclerosis Having Thrombosis. PMID: 29130325
- vWF acts as a simple prognostic biomarker in AF and, whilst its addition to current scores statistically improves prediction for some endpoints, absolute changes and impact on clinical decision-making are marginal. PMID: 28134282
- The aim of the study was to investigate the role of von Willebrand factor (vWF), the vWF-cleaving protease, ADAMTS13, the composition of thrombus, and patient outcome following mechanical cerebral artery thrombectomy in patients with acute ischemic stroke. PMID: 29887594
- High vWF plasma concentrations may discriminate patients with non-valvular atrial fibrillation at greater risk of stroke or all-cause death. PMID: 29685722
- Coronary artery disease patients exhibited significantly lower plasma BDNF and higher vWF levels than those of control patients. PMID: 29409455
- A discontinuous autoinhibitory module masks the A1 domain of von Willebrand factor, preventing binding to GPIba. PMID: 28692141
- VWF, GMP-140, ADAMTS13 and the cerebral vasospasm, delayed cerebral ischemia, tumor diameter and prognosis of aneurysmal subarachnoid hemorrhage patients are closely related PMID: 29077161
- von Willebrand Factor is steadily elevated throughout the course of dysrhythmia in NVAF patients treated with warfarin and in those with higher intensity of left atrium blood stasis. PMID: 28952167
- The levels of VWF-cleaving protease ADAMTS13 among neonates were higher as compared with healthy adults, despite a significant elevation of VWF antigen (Ag) and Ristocetin cofactor (RiCof) noted in all neonates. PMID: 28087247
- The pathogenic effects of candidate VWF gene mutations were explored in this study. Molecular dynamic simulations on p.M771I mutant VWF revealed distinct structural rearrangements including a large deviation in the E' domain, and significant loss of beta-sheet secondary structure. PMID: 27483487
- investigated the roles of ADAMTS13 and VWF in thrombotic events of patients with Connective Tissue Diseases PMID: 26759371
- vWF had a significant prognostic impact on cardiovascular mortality when OPG levels were low. Low levels of both OPG and act vWF were associated with a 99 % survival rate during the follow-up of five years. PMID: 28726980
- Studied the significance of the von Willebrand factor (VWF)/ ADAMTS-13 ratio in advanced non-small-cell lung cancer (NSCLC). Findings suggest that the imbalance between VWF secretion and ADAMTS-13 may play a role in the hypercoagulability state in advanced NSCLC, and increase of the plasma VWF/ADAMTS-13 ratio may serve as an independent predictive factor for mortality in patients with advanced NSCLC. PMID: 28374895
- Type 3 von Willebrand disease patients with the Pro2808Leufs*24 have bioavailable platelet-derived VWF that may produce a milder bleeding phenotype than other type 3s PMID: 28453889
- vaso-occlusive crisis in sickle cell disease is associated with increased reactivity of VWF, without a pronounced ADAMTS-13 deficiency PMID: 28457019
- Overexpression of factor VIII-RA in the endothelial cells of capillary like vessels in the periphery of central and peripheral giant cell granuloma of jaw was prominent. PMID: 28832079
- Different patterns of VWF multimer loss were seen in heart failure patients treated with implantation of left ventricular assist device and total artificial heart, which may contribute to bleeding patterns. PMID: 28586149
- A high degree of clinical and laboratory variability exists within type 2M von Willebrand disease variants. PMID: 28544236
- Complex VWF-ADAMTS13-mediated mechanisms disturb haemostasis in inflammatory bowel disease. PMID: 28765701
- PP2B-Aalpha-Munc18c complex supports agonist-induced VWF secretion by HUVECs. PMID: 28294518
- Deficiency of the von Willebrand factor-cleaving protease ADAMTS13 is central to the pathophysiology of thrombotic thrombocytopenic purpura. Reviewed is the evidence emerged from epidemiological studies of an inverse relationship between the plasma levels of ADAMTS13 and the risk of acute coronary syndrome. [review] PMID: 28521259
- genetic variation of vWF V1565L polymorphism modulates ADAMTS13 activity. PMID: 27536857
- Plasma levels of VWF antigen and activity are significantly increased with concomitant reduction in plasma ADAMTS13 activity in patients with subarachnoid haemorrhage. PMID: 28102428
- Report a diagnostic algorithm that can reliably identify pathogenic variants of factor 8/9 and von Willebrand factor and diagnose patients with hemophilia A, hemophilia B or von Willebrand disease. PMID: 27734074
- analysis of an artificial botrocetin that can inhibit the VWF-GPIb interaction PMID: 28071872
- VWF binding to MMRN1 was enhanced by shear exposure and ristocetin, and required VWF A1A2A3 region, specifically the A1 and A3 domains. PMID: 27052467
- coronary thrombi in STEMI patients resistant to fibrinolysis are characterised by higher fibrin, P-selectin and VWF content than lysis-sensitive thrombi PMID: 26962963
- We compared the classical Sanger sequencing approach and NGS to assess the value-added effect on the analysis of the mutation distribution in different types of VWD. Sixty-two different VWF mutations were identified, 27 of which had not been previously described. NGS detected 26 additional mutations, contributing to a broad overview of the mutant alleles present in each VWD type. PMID: 26988807
- These observations support the hypothesis that a significantly reduced ADAMTS13/VWF ratio in the coronary artery flow plays a pathogenic role in acute coronary syndromes (ACS) and suggest that transition from laminar to turbulent flow at sites of coronary stenosis further enhances VWF activation and deposition. PMID: 27034431
- the major genetic factors affecting plasma VWF levels, i.e. variants at ABO, VWF and a locus on chromosome 2, operate primarily through their effects on VWF clearance PMID: 27359253
- The unique phenotype of VWD2 type IIC-Miami results from dominant impairment of multimer assembly, an aberrant structure of mutant mature VWF and reduced clearance in vivo PMID: 27344059
- Low ADAMTS-13 activity is associated with an increased risk of coronary heart disease in the elderly, independently of VWF and established cardiovascular risk factors PMID: 27559008
- Very low birth weight preterm neonates have increased numbers of platelets interacting with von Willebrand Factor, and increased GPIbalpha expression on the platelet surface PMID: 27416003
- N-linked glycan truncation causes enhanced clearance of plasma-derived von Willebrand factor; variation in VWF glycosylation may be important in the pathophysiology underlying type 1C VWD PMID: 27732771
- Data suggest that an aspartate at position 1261 is the most critical residue of VWF N-terminal linker for inhibiting binding of VWF A1 domain to GP1BA on platelets in a model simulating blood flow velocity; network of salt bridges between Asp1261 and rest of VWF A1 domain lock N-terminal linker in place such that binding to GP1BA is reduced. PMID: 28924049
- In people with dysglycaemia and other cardiovascular risk factors, basal insulin does not improve the levels of markers of fibrinolysis or von Willebrand factor compared to standard glucose-lowering treatments. PMID: 28403644
- low VWF levels can be associated with significant bleeding and are predominantly due to reductions in VWF synthesis and/or constitutive secretion. PMID: 28916584
- Refrigeration-induced binding of VWF to platelets facilitates their rapid clearance by inducing GPIbalpha-mediated signaling. PMID: 29097365
- Data show that von Willebrand factor (VWF) is first converted from a compact to linear form by flow, and is subsequently activated to bind platelet glycoprotein Ib alpha polypeptide (GPIbalpha) in a tension-dependent manner. PMID: 28831047
- The >30 nm macroglycopeptide separating the two domains of GPIbalpha transmits force on the VWF-GPIbalpha bond (whose lifetime is prolonged by leucine-rich repeat domain unfolding) to the juxtamembrane mechanosensitive domain to enhance its unfolding, resulting in unfolding cooperativity at an optimal force. PMID: 27434669
- von Willebrand factor processing and function has been summarized using various biophysical techniques. (Review) PMID: 27717713
- Soluble VWF was statistically elevated in major depressive disorder. PMID: 27598970
- Rare genetic variants in the ADAMTS13 on Willebrand factor-binding domain contribute to pediatric stroke. PMID: 27412500
- results indicate that VWF multimer accumulation on endothelium, as occurs in congenital thrombotic thrombocytopenic purpura, promotes the activation of the complement alternative pathway that proceeds until C5 cleavage with the formation of C5a and the terminal C5b-9 complex PMID: 28652401
- Findings also identify VWF as a new complement regulator on vascular endothelial cells and suggest that VWF has a protective effect on endothelial cells and complement-mediated injury. PMID: 27236750
- LVAD recipients achieved a new hemostatic equilibrium characterized by infrequent major hemorrhagic and thrombotic events, despite a mildly impaired vWF function and a markedly enhanced thrombin formation. PMID: 27485105
- These results demonstrate that cancer cells of non-endothelial origin can acquire de novo expression of VWF, which can enhance processes, including endothelial and platelet adhesion and extravasation, that contribute to cancer metastasis. PMID: 28035064
- level of vWF-ag in the chronic phase correlated with the amounts of VAT and PAT, but not with subcutaneous adipose tissue PMID: 28570705
- both in acute and chronic cerebrovascular disease patients, ADAMTS13 levels were significantly decreased, with the lowest ADAMTS13 levels found in acute stroke patients. This difference was even more distinct when the ratio of VWF:ADAMTS13 was considered. These results demonstrate the potentially important involvement of the VWF/ADAMTS13 axis in ischemic stroke. PMID: 28591212
顯示更多
收起更多
-
相關(guān)疾病:von Willebrand disease 1 (VWD1); von Willebrand disease 2 (VWD2); von Willebrand disease 3 (VWD3)
-
亞細(xì)胞定位:Secreted. Secreted, extracellular space, extracellular matrix. Note=Localized to storage granules.
-
組織特異性:Plasma.
-
數(shù)據(jù)庫(kù)鏈接:
Most popular with customers
-
-
YWHAB Recombinant Monoclonal Antibody
Applications: ELISA, WB, IHC, IF, FC
Species Reactivity: Human, Mouse, Rat
-
-
-
-
-
-